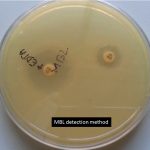
MBL detection method
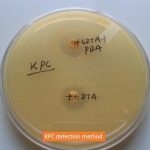
KPC detection method

Collection Group: Clinical Bacteriology
MBL: Introduction, Mechanism of Action, Family and Detection Methods
Introduction of MBL MBL stands for Metallo β- lactamase and...
Introduction of MBL MBL stands for Metallo β- lactamase and...
Klebsiella pneumoniae Carbapenemases (KPC): Introduction, Importance, Detection and Treatment
Introduction of Klebsiella pneumoniae carbapenemase (KPC) Klebsiella pneumoniae carbapenemase (KPC) is...
Introduction of Klebsiella pneumoniae carbapenemase (KPC) Klebsiella pneumoniae carbapenemase (KPC) is...
ESBL: Introduction, Detection Methods and Treatment Options
 Introduction of ESBL ESBL stands for Extended-spectrum β- lactamase. In modern medical...
Introduction of ESBL ESBL stands for Extended-spectrum β- lactamase. In modern medical...
